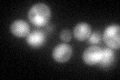
YMR311C
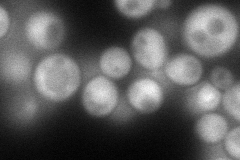
YMR311C
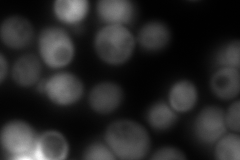
YMR311C
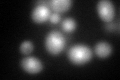
YMR311C
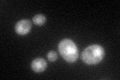
YMR311C

View description
Regulatory subunit of protein phosphatase 1 (Glc7p), involved in glycogen metabolism and chromosome segregation; proposed to regulate Glc7p activity via conformational alteration; ortholog of the mammalian protein phosphatase inhibitor 2
Localization:
Intensity:
Fold change:
Significance:
-
C’ GFP library in SD
nucleus:cytosol77.75 -
N' NOP1pr-GFP in SD
cytosol115.618 -
N' TEF2pr-mCherry in SD
cytosol4.41816 -
N' NATIVEpr-GFP in SD

cytosol56.0169 -
N' TEF2pr-VC and Cyto-VN in SD

cytosol64.7352 -
C’ GFP library in SD+DTT
nucleus.cytosol97.241.25No -
C’ GFP library in SD+H2O2

nucleus.cytosol71.920.92No -
C’ GFP library in Starvation Media
nucleus,cytosol109.541.4Yes -
C’ GFP library on the background of Pup2-DaMP

nucleus:cytosol -
C’ GFP library on the background of CCT mutant

nucleus:cytosol72.91680.937777No
